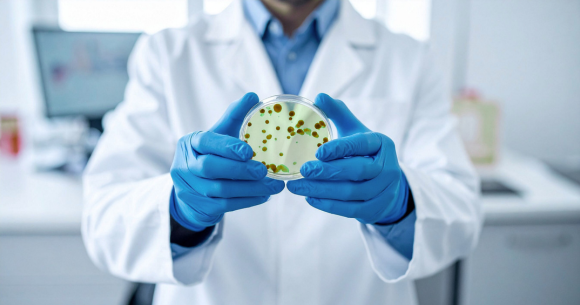

Análise de Ar Climatizado em Data Centers
Controle ambiental, saúde ocupacional e eficiência energética
A análise de ar climatizado em Data Centers precisa atender dois objetivos ao mesmo tempo: manter os equipamentos operando de forma confiável e proteger a saúde das pessoas que trabalham no local.
Isso significa ir além do básico de temperatura e umidade, envolve controle de partículas, renovação do ar, avaliação microbiológica e conforto térmico especialmente em salas técnicas e corredores de circulação.
Na operação, o reflexo é: menos falhas operacionais, maior eficiência energética e um ambiente mais saudável para as equipes.
O crescimento do setor de Data Centers no mundo e no Brasil
Cenário global
O setor global de Data Centers está crescendo rápido. A expectativa é que a capacidade mundial dobre nos próximos cinco anos, puxada principalmente pelas gigantes de tecnologia Google, Microsoft, Amazon e Meta.
Os Estados Unidos lidera essa corrida, com mais de 3.700 data centers, seguido por Reino Unido e Alemanha.
Principais hubs no mundo:
- Northern Virginia (EUA): o maior hub global, com a maior concentração de fibra e capacidade energética
- FLAP-D (Europa): Frankfurt, Londres, Amsterdã, Paris e Dublin formam o coração da infraestrutura europeia
- Singapura e Tóquio (Ásia): pontos estratégicos para o tráfego de dados na região do Pacífico
Cenário brasileiro
O Brasil se consolidou como o gigante digital da América Latina. Detém a maior fatia do mercado regional entre 112 e 120 data centers de grande porte, operados por 23 grandes players e vem atraindo investimentos bilionários, favorecido pela matriz energética limpa e localização estratégica.
Principais hubs no Brasil:
- São Paulo e Campinas: concentram a maior parte da infraestrutura nacional, pela proximidade com o centro financeiro e infraestrutura elétrica robusta.
- Rio de Janeiro: segundo maior hub e conectividade submarina.
- Fortaleza: hub estratégico de cabos submarinos, conectando o Brasil diretamente à Europa e aos Estados Unidos.
Por que realizar análise de ar climatizado em Data Centers?
Passamos boa parte do dia em ambientes fechados, com ar-condicionado e pouca troca de ar com o exterior. Quando muita gente circula no mesmo espaço, os riscos aumentam.
Riscos microbiológicos
Lugares com concentração de pessoas facilitam a circulação de bactérias, vírus e fungos. Em Data Centers, isso acontece principalmente nas áreas onde as equipes ficam mais tempo, NOC (Network Operations Center), salas técnicas, escritórios internos e em pontos onde acumula umidade e sujeira: filtros que não são trocados, bandejas de condensação, dutos mal mantidos.
Riscos físico-químicos
Pouca renovação de ar somada ao fluxo de pessoas eleva a concentração de CO₂. Isso interfere em temperatura, umidade e velocidade do ar, causando desconforto e queda de produtividade.
Ignorar a qualidade do ar pode resultar em:
- Doenças respiratórias
- Alergias
- Absenteísmo
Manter o ar sob controle protege as pessoas e sustenta a operação.
Diretrizes internacionais: ISO/IEC 22237-4 e ASHRAE TC 9.9
ISO/IEC 22237-4:2021 (requisitos normativos)
A ISO/IEC 22237-4:2021 estabelece os requisitos de controle ambiental para Data Centers, com base em critérios de disponibilidade, segurança e eficiência energética definidos na ISO/IEC 22237-1.
A norma cobre:
a) controle de temperatura
b) controle do movimento de fluidos
c) controle da umidade relativa
d) controle de partículas
e) vibração
f) segurança física dos sistemas de controle ambiental
ASHRAE TC 9.9 (diretrizes operacionais)
As diretrizes técnicas da ASHRAE TC 9.9 recomendam as condições que equilibram confiabilidade dos equipamentos e economia de energia.
Faixas recomendadas:
- Temperatura de entrada: 18°C a 27°C
- Umidade relativa: 20% a 80% (atenção especial em ambientes propensos à corrosão)
- Ponto de orvalho: máximo de 22°C (evita condensação)
Por que isso importa? Operar fora dessas faixas compromete confiabilidade e eficiência.
Detalhe importante: o que conta para o hardware é a temperatura de entrada nos equipamentos (inlet), não a temperatura média da sala.
Riscos de uma climatização inadequada em Data Centers
Quando a análise de ar é inexistente, os problemas aparecem em várias frentes:
- Técnica: superaquecimento, redução forçada de desempenho e falhas de hardware
- Operacional: paradas não planejadas, perda de dados, vida útil reduzida dos equipamentos
- Financeira: consumo energético maior e custos com substituição prematura
- Sustentabilidade: desperdício de energia, dificuldade para atingir metas ESG
Impacto na vida útil dos equipamentos em Data Centers
Ambiente controlado significa equipamento durando mais. Uma regra prática da indústria: um aumento constante de 10°C acima do ideal pode reduzir bastante a vida útil de componentes eletrônicos, forçando trocas antecipadas e aumentando custos.
Além disso:
- Umidade muito baixa aumenta o risco de descarga eletrostática (ESD)
- Umidade alta acelera a corrosão de componentes metálicos
Resumindo: controlar temperatura, umidade e partículas é questão de confiabilidade, não somente de conforto e segurança.
O escopo de Análise de Ar da Microambiental para Data Centers
A Microambiental realiza análise da qualidade do ar interno seguindo a ABNT NBR 17037, a principal norma brasileira para controle de qualidade do ar em ambientes climatizados de uso público e coletivo.
O que analisamos
Pesquisa e contagem de fungos
Verificamos a presença de fungos patogênicos e toxigênicos. A avaliação inclui gêneros como Aspergillus sp, Penicillium sp, Trichophyton sp, Candida sp, Fusarium sp, Mucor sp, Mycelia sterilia, entre outros.
Contagem de bactérias mesófilas
Indicador de carga microbiana em ambientes ocupados.
Concentração de CO₂
Mostra se o ar está sendo renovado adequadamente.
Partículas em suspensão (PM10 e PM2,5)
Partículas inaláveis que afetam a saúde respiratória.
Temperatura, umidade e velocidade do ar
Verifica se há conforto térmico para quem ocupa o espaço.
Como funciona
- Equipe especializada coleta amostras nos pontos certos, sem contaminar
- Equipamentos a bateria e silenciosos, sem incomodar quem está trabalhando
- Suporte técnico para interpretar os resultados e propor ações
- Laudos digitais acessíveis via portal em nuvem
Benefícios do serviço de análise de ar da Microambiental
Temos uma equipe técnica especializada em análises de ar em ambiente climatizado, preparada para realizar a coleta nos pontos adequados e seguindo procedimentos que evitam qualquer contaminação das amostras.
Equipamentos modernos:
Utilizamos equipamentos de amostragem alimentados por bateria, com baixo nível de ruído, o que facilita a operação e reduz o impacto para quem está no ambiente.
Suporte para interpretar os resultados:
Contamos com uma equipe de Atendimento Técnico que presta apoio na leitura dos resultados e na proposição de ações para corrigir as não conformidades.
Acesso prático aos laudos:
Os resultados ficam armazenados em nuvem e são disponibilizados em um portal online, permitindo consulta de qualquer lugar, a qualquer momento.
Conclusão
A análise de ar climatizado em Data Centers precisa olhar para o ambiente por completo: controle ambiental para garantir disponibilidade e eficiência, e qualidade do ar para proteger as pessoas.
Com medições corretas e laudos que orientam decisões, você reduz riscos, melhora a operação e demonstra governança sobre um ambiente crítico.
Garanta a qualidade do ar no seu Data Center. Fale com nossos especialistas.
Fontes: Data Center Outlook Data Center Market Size, Share, and Trends 2026 to 2035 2026 Data Centre Outlook: The Top Five Trends Reshaping Global Markets 2026 Global Data Center Market Outlook Global Data Center Market Statistics and Forecasts Data Center Market Will Expand 14% In 2026; Report Data Center Expansion in Latin America: Growth and Opportunities in Brazil Brazil Data Center Market Size & Share Outlook to 2031 Brazil’s $377B Data Center Incentives Plan Key Telecom Trends in Brazil for 2026 Brazil Data Center Market: Size, Share, Growth and Analysis Capturing the Data Center Opportunity in Latin America and the Caribbean ISO/IEC 30134-7:2023 ISO/IEC 22237-4:2021 Equipment Thermal Guidelines for Data Processing Environments ASHRAE Recommended Data Center Temperature & Humidity Data Center Temperature and Humidity Guidelines